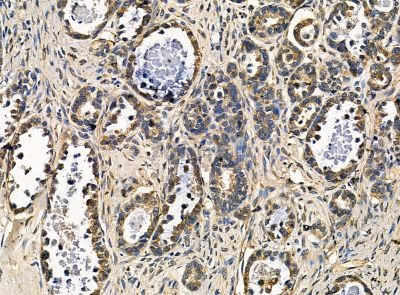
alpha COP I Antibody - DF14201 at 1/100 staining human ovarian cancer by IHC-P.
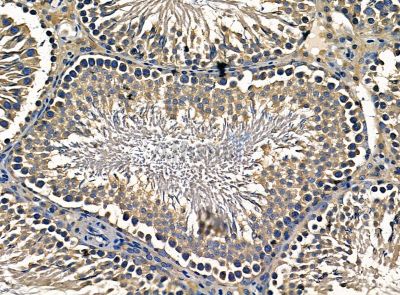
alpha COP I Antibody - DF14201 at 1/100 staining rat testis tissue by IHC-P.

alpha COP I Antibody - #DF14201
Related Downloads
Protocols
Product Info
*The optimal dilutions should be determined by the end user. For optimal experimental results, antibody reuse is not recommended.
*Tips:
WB: For western blot detection of denatured protein samples. IHC: For immunohistochemical detection of paraffin sections (IHC-p) or frozen sections (IHC-f) of tissue samples. IF/ICC: For immunofluorescence detection of cell samples. ELISA(peptide): For ELISA detection of antigenic peptide.
Fold/Unfold
Alpha coat protein; Alpha COP; Alpha COPI; Alpha-coat protein; Alpha-COP; AlphaCOP; Coatomer protein complex subunit alpha; Coatomer subunit alpha; COP A; COP I alpha; copA; COPA_HUMAN; COPI alpha; FLJ26320; HEP COP; HEP-COP; HEPCOP; Proxenin; Xenin; Xenopsin-related peptide;
Immunogens
A synthesized peptide derived from Human alpha COP I.
Uniformly expressed in a wide range of adult and fetal tissues. Xenin is found in gastric, duodenal and jejunal mucosa. Circulates in the blood. Seems to be confined to specific endocrine cells.
- P53621 COPA_HUMAN:
- Protein BLAST With
- NCBI/
- ExPASy/
- Uniprot
MLTKFETKSARVKGLSFHPKRPWILTSLHNGVIQLWDYRMCTLIDKFDEHDGPVRGIDFHKQQPLFVSGGDDYKIKVWNYKLRRCLFTLLGHLDYIRTTFFHHEYPWILSASDDQTIRVWNWQSRTCVCVLTGHNHYVMCAQFHPTEDLVVSASLDQTVRVWDISGLRKKNLSPGAVESDVRGITGVDLFGTTDAVVKHVLEGHDRGVNWAAFHPTMPLIVSGADDRQVKIWRMNESKAWEVDTCRGHYNNVSCAVFHPRQELILSNSEDKSIRVWDMSKRTGVQTFRRDHDRFWVLAAHPNLNLFAAGHDGGMIVFKLERERPAYAVHGNMLHYVKDRFLRQLDFNSSKDVAVMQLRSGSKFPVFNMSYNPAENAVLLCTRASNLENSTYDLYTIPKDADSQNPDAPEGKRSSGLTAVWVARNRFAVLDRMHSLLIKNLKNEITKKVQVPNCDEIFYAGTGNLLLRDADSITLFDVQQKRTLASVKISKVKYVIWSADMSHVALLAKHAIVICNRKLDALCNIHENIRVKSGAWDESGVFIYTTSNHIKYAVTTGDHGIIRTLDLPIYVTRVKGNNVYCLDRECRPRVLTIDPTEFKFKLALINRKYDEVLHMVRNAKLVGQSIIAYLQKKGYPEVALHFVKDEKTRFSLALECGNIEIALEAAKALDDKNCWEKLGEVALLQGNHQIVEMCYQRTKNFDKLSFLYLITGNLEKLRKMMKIAEIRKDMSGHYQNALYLGDVSERVRILKNCGQKSLAYLTAATHGLDEEAESLKETFDPEKETIPDIDPNAKLLQPPAPIMPLDTNWPLLTVSKGFFEGTIASKGKGGALAADIDIDTVGTEGWGEDAELQLDEDGFVEATEGLGDDALGKGQEEGGGWDVEEDLELPPELDISPGAAGGAEDGFFVPPTKGTSPTQIWCNNSQLPVDHILAGSFETAMRLLHDQVGVIQFGPYKQLFLQTYARGRTTYQALPCLPSMYGYPNRNWKDAGLKNGVPAVGLKLNDLIQRLQLCYQLTTVGKFEEAVEKFRSILLSVPLLVVDNKQEIAEAQQLITICREYIVGLSVETERKKLPKETLEQQKRICEMAAYFTHSNLQPVHMILVLRTALNLFFKLKNFKTAATFARRLLELGPKPEVAQQTRKILSACEKNPTDAYQLNYDMHNPFDICAASYRPIYRGKPVEKCPLSGACYSPEFKGQICRVTTVTEIGKDVIGLRISPLQFR
Research Backgrounds
The coatomer is a cytosolic protein complex that binds to dilysine motifs and reversibly associates with Golgi non-clathrin-coated vesicles, which further mediate biosynthetic protein transport from the ER, via the Golgi up to the trans Golgi network. Coatomer complex is required for budding from Golgi membranes, and is essential for the retrograde Golgi-to-ER transport of dilysine-tagged proteins. In mammals, the coatomer can only be recruited by membranes associated to ADP-ribosylation factors (ARFs), which are small GTP-binding proteins; the complex also influences the Golgi structural integrity, as well as the processing, activity, and endocytic recycling of LDL receptors (By similarity).
Xenin stimulates exocrine pancreatic secretion. It inhibits pentagastrin-stimulated secretion of acid, to induce exocrine pancreatic secretion and to affect small and large intestinal motility. In the gut, xenin interacts with the neurotensin receptor.
Cytoplasm. Golgi apparatus membrane>Peripheral membrane protein>Cytoplasmic side. Cytoplasmic vesicle>COPI-coated vesicle membrane>Peripheral membrane protein>Cytoplasmic side.
Note: The coatomer is cytoplasmic or polymerized on the cytoplasmic side of the Golgi, as well as on the vesicles/buds originating from it.
Secreted.
Uniformly expressed in a wide range of adult and fetal tissues. Xenin is found in gastric, duodenal and jejunal mucosa. Circulates in the blood. Seems to be confined to specific endocrine cells.
Restrictive clause
Affinity Biosciences tests all products strictly. Citations are provided as a resource for additional applications that have not been validated by Affinity Biosciences. Please choose the appropriate format for each application and consult Materials and Methods sections for additional details about the use of any product in these publications.
For Research Use Only.
Not for use in diagnostic or therapeutic procedures. Not for resale. Not for distribution without written consent. Affinity Biosciences will not be held responsible for patent infringement or other violations that may occur with the use of our products. Affinity Biosciences, Affinity Biosciences Logo and all other trademarks are the property of Affinity Biosciences LTD.